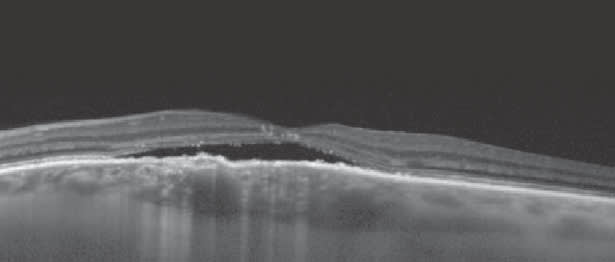

Treatment Failure or Misdiagnosis?
When other conditions mimic wet AMD, spectral domain OCT provides detailed views for an accurate diagnosis.

By Peter K. Kaiser, MD
A 60-year-old patient diagnosed with wet age-related macular degeneration (AMD) and receiving anti-VEGF injections is not responding to treatment and presents for a second opinion.
This has become a familiar scenario in my practice, and often, the question becomes: Was the initial diagnosis correct? Several diseases can mimic wet AMD in this patient population and will not respond to anti-VEGF therapy. Spectral domain optical coherence tomography (SD-OCT) helps us differentiate some of these conditions. Here are three diseases that are commonly mistaken for wet AMD.
Chronic Central Serous Retinopathy
Atypical or chronic central serous retinopathy (CSR) can resemble wet AMD in a 60-year-old patient, but SD-OCT will make the diagnosis apparent (Figure 1). Even in the presence of a pigment epithelial detachment and subretinal fluid, imaging the choroid is key.
A thickened choroid will confirm a diagnosis of CSR and not wet AMD (Figure 1). To image the choroid, one can use enhanced depth imaging or pixel optimization (as with the Cirrus HD-OCT).
Figure 1. A 60-year-old patient was being treated with monthly intravitreal anti-VEGF for wet AMD based on the presence of subretinal fluid. He presented for a second opinion because the fluid was not resolving. As you can see on SD-OCT, the choroidal thickness is greatly increased, indicating the correct diagnosis is central serous retinopathy, not wet AMD. No additional injections were given. If the fluid persists, photodynamic therapy could be considered.
Adult Vitelliform Dystrophy
Clinically, adult vitelliform dystrophy looks like wet AMD, with an elevation of the retina that can be mistaken for subretinal fluid. I frequently see patients who are seeking a second opinion because they have been receiving anti-VEGF injections for AMD but have not been responding. Some of these patients actually have adult vitelliform dystrophy, which is not helped by anti-VEGF injections. On OCT, adult vitelliform dystrophy has a characteristic appearance (Figure 2). Once you recognize it, it is easy to see and understand. Similarly, if you do not see choroidal neovascularization on OCT, the patient may not have AMD.

Figure 2. This patient was treated with monthly anti-VEGF injections for almost a year before seeking a second opinion. Although the features, especially in an older patient, can be similar, the vitelliform lesion has a characteristic appearance on SD-OCT that differentiates it from choroidal neovascularization.
Outer Retinal Tubulation
Patients who have been undergoing anti-VEGF therapy may develop something that looks like cysts or subretinal fluid on clinical examination. A closer look, using SD-OCT, may reveal what is really outer retinal tubulation (Figure 3), which is not helped with additional anti-VEGF therapy. Looking at the entire 3-D cube scan, particularly the Z plane view, will confirm this diagnosis.

Figure 3. This patient was treated with numerous anti-VEGF injections, and the question is whether additional injections are required. The circular spaces seen on this OCT image represent outer retinal tubulation and not cystoid macular edema. Outer retinal tubulation does not respond to anti-VEGF injections, and this patient can be watched.
Look Closely
Spectral domain OCT is a powerful diagnostic tool, particularly for differential diagnosis of AMD. I encourage clinicians to take full advantage of the images and data generated by this technology to aid in an accurate diagnosis. ■
Images courtesy of Siya Huo and Peter Kaiser, MD, Cole Eye Institute, Cleveland, Ohio
Dr. Kaiser is a professor of ophthalmology, Cleveland Clinic Lerner College of Medicine. He is a consultant to Carl Zeiss Meditec. He can be reached at pkkaiser@aol.com.








